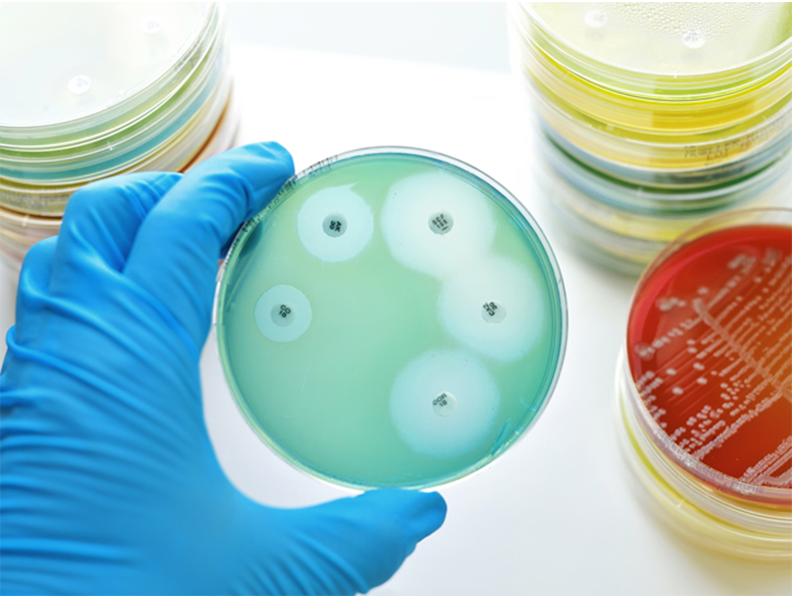
crf2_792_598

Institute of Molecular Functional Materials
MissionInstitute of Molecular Functional Materials is dedicated to bring together inter-institutional efforts from the area of synthetic, polymer, material and physical chemistry, and interdisciplinary expertise through national/international collaboration in physics and device engineering towards developing an international eminent research centre in the area of molecular functional materials. In addition, the Institute aims to address some of the grand challenges in energy-related issues with particular emphasis on the fundamental study and understanding from the chemistry perspectives and to provide a forum for exchanges, which may serve as a spawning ground for technology transfer to empower local/regional industries to develop high-technology. |
For more information about the Institute, please visit https://chemistry.hku.hk/imfm/ |
Goals
-
To forge a multi-institutional and multidisciplinary collaborative team on molecular functional materials research.
-
To strategically develop research on molecular functional materials through collaborative interactions and strategic alliance with regional/international research groups.
-
To generate new knowledge in the chemistry and functional properties of innovative molecular materials with potential practical applications to address some of the grand challenges in energy-related issues.
-
To invent new patentable materials to assist high-technology development.
-
To educate students in the science and technology of molecular materials and their relevance to energy and the environment.
-
To disseminate the most recent discoveries and their implications to the scientific community, and to advance the public understanding of science and technology and how chemistry can contribute to the society.

HKU-CAS Joint Laboratory on New Materials

The HKU-CAS Joint Laboratory on New Materials is dedicated to providing young scientists from Chinese Academy of Sciences and researchers at the University of Hong Kong with a well-equipped research platform for fostering interdisciplinary research at HKU and promoting national and international collaborations. The objective of the Joint Laboratory is to develop innovative Photo-Functional Molecular Materials and Practical Photo-Catalysts for Light to Chemical Conversion. The research programs entail synthetic chemistry, photochemistry and excited state dynamics of molecular materials, hybrid materials and artificial photosynthetic systems.

State Key Laboratory of Synthetic Chemistry

The SKL of Synthetic Chemistry provides a platform for the creation/invention of new functional molecules with novel bonding, structures and properties, and for application studies of these newly invented/prepared molecules. The objectives of the SKL are (i) to develop Green and Sustainable Catalysis with practical applications, and (ii) to develop/identify applications of the newly invented functional molecules in the areas of Materials Science and Medicines.

Challenges in Organic Photo-Voltaics and Light Emitting Diodes
MissionThe Theme-Based Research Scheme Project on "Challenges in Organic Photo-Voltaics and Light Emitting Diodes – A Concerted Multi-Disciplinary and Multi-Institutional Effort" is dedicated to bring together multi-disciplinary and multi-institutional efforts from the areas of chemistry, physics, materials science and engineering towards developing novel materials and technologies for emerging OLED and OPV fields. In addition, this project aims to address some of the grand challenges in energy-related issues with particular emphasis towards the development of clean renewable energy and sustainable environment. |
For more information about this project, please visit https://chemistry.hku.hk/tbrs/ |
Goals
- Develop new patentable materials for emerging OLED and OPV fields
- Provide new knowledge in the chemistry and device engineering for the performance enhancement of OLEDs and OPVs
- Accelerate and foster multi-disciplinary research collaboration among different research fields
- Create national- and Hong Kong-owned intellectual rights and patents and provide knowledge and technology transfer to research community
- Educate students in the science and technology of OLEDs and OPVs and their relevance to energy and the environment
- Improve the image of Hong Kong as a city of high clean renewable energy and environment awareness
Total synthesis and medicinal chemistry of cyclic peptide-based antibacterial compounds



